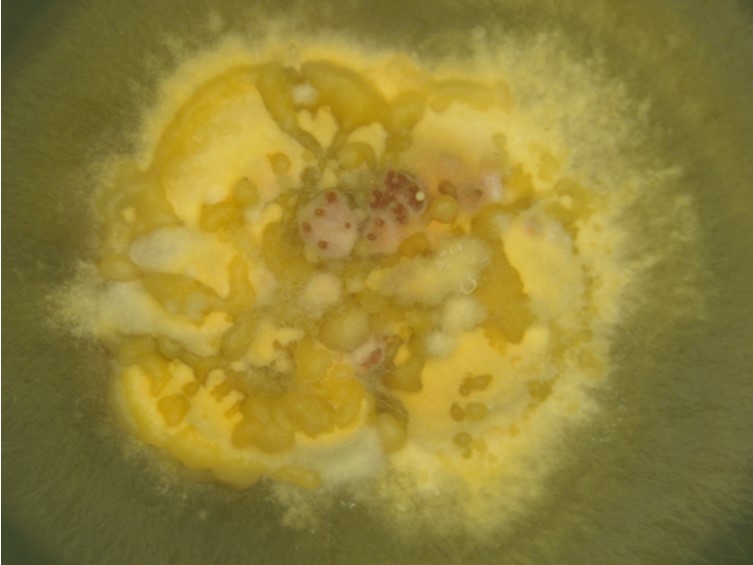

Habitat:
Underside of dicotyledonous leaves, twig of trees.
Host:
Scale insect nymphs (Hemiptera).
Description:
 Sexual morph: stromata hemispherical, up to 3 mm in diam and up to 2 mm high, when fresh yellow brown and becoming dark brown when old.
Sexual morph: stromata hemispherical, up to 3 mm in diam and up to 2 mm high, when fresh yellow brown and becoming dark brown when old.  Perithecium several in each tubercle, ostiola red brown, slightly projecting, flask shape, up to 550 µm long, up to 350 diam.
Perithecium several in each tubercle, ostiola red brown, slightly projecting, flask shape, up to 550 µm long, up to 350 diam.  Asci cylindrical, 175 × 10-12 µm wide. Ascospores divide into part-spores, 7.5-10 × 2-3 µm, cylindrical oblong-oval, end round.
Asci cylindrical, 175 × 10-12 µm wide. Ascospores divide into part-spores, 7.5-10 × 2-3 µm, cylindrical oblong-oval, end round.  Asexual morph: stromata pycnidia embedded singly in stromata, mostly central but could also be peripheral, up to 50 um in diam. When fresh a copious mass of yellow to orange
Asexual morph: stromata pycnidia embedded singly in stromata, mostly central but could also be peripheral, up to 50 um in diam. When fresh a copious mass of yellow to orange  conidia was extruded from pycnidia. Paraphyses are absent.
conidia was extruded from pycnidia. Paraphyses are absent.  Phialides slender, up to 17.5 × 1.5-2 µm. Conidia hyaline, narrow, fusoid, ends tapering, 7-10 × 2 µm. The conidia of Thai specimens were smaller than those described by Petch (1921).
Phialides slender, up to 17.5 × 1.5-2 µm. Conidia hyaline, narrow, fusoid, ends tapering, 7-10 × 2 µm. The conidia of Thai specimens were smaller than those described by Petch (1921).
Culture characteristics:
Colony on PDA attaining a diam of 5 mm after 4 wk, pale yellow. Sporulation begins after 4 wk from pycnidia.
Colony on PDA attaining a diam of 5 mm after 4 wk, pale yellow. Sporulation begins after 4 wk from pycnidia.
Reference:
Chaverri P, Liu M, Hodge KT (2008). A monograph of the entomopathogenic genera Hypocrella, Moelleriella, and Samuelsia gen. nov. (Ascomycota, Hypocreales, Clavicipitaceae), and their aschersonia-like anamorphs in the Neotropics. Studies in Mycology 60: 1–66.
DOI: https://dx.doi.org/10.3114/sim.2008.60.01Petch T (1921). Studies in entomogenous fungi: II. The genera Hypocrella and Aschersonia. Annals of the Royal Botanic Gardens Peradeniya 7: 167–278.
Species |
Strain |
Compound |
Pubchem CID |
Biological activity |
Reference |
|---|
|
Strain |
|---|